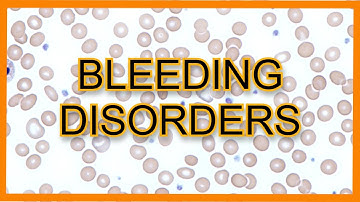
Bleeding Disorders (ITP vs TTP vs HUS vs DIC) || USMLE

⬇ DOWNLOAD NOW
Kalau muncul iklan pop-up, tutup lalu klik tombol kembali
Download lagu MTH301 Lecture 43 (Functions With Periods Other Than 2pi) (Detailed) secara gratis hanya untuk keperluan promosi. Dukung artis favorit kamu dengan membeli musik original di iTunes atau platform resmi lainnya.
 Mth301 Short Lecture 43 | Fourier Series Of Periodic Functions | Calculus 2 | Vu Smart Learning
Mth301 Short Lecture 43 | Fourier Series Of Periodic Functions | Calculus 2 | Vu Smart Learning
Bleeding Disorders (ITP vs TTP vs HUS vs DIC) || USMLE
Bleeding Disorders (ITP vs TTP vs HUS vs DIC) || USMLE
 MTH301 Lecture 45 | MTH201 Lecture 45 | Kinza Bilal | Education World
MTH301 Lecture 45 | MTH201 Lecture 45 | Kinza Bilal | Education World
 Current Final Term 2020 Papers collection.| BY EHTISHAM.
Current Final Term 2020 Papers collection.| BY EHTISHAM.
 MTH301 Lecture 45 (Theorems) (Part 1) (Detailed)
MTH301 Lecture 45 (Theorems) (Part 1) (Detailed)
 MTH301 Lecture 44 (Laplace Transforms) (IMPORTANT) (Detailed)
MTH301 Lecture 44 (Laplace Transforms) (IMPORTANT) (Detailed)
 Monitoring the Menstrual Cycle With a DUTCH Cycle Map
Monitoring the Menstrual Cycle With a DUTCH Cycle Map
 MTH301 Lecture 28 (Limits of vector valued functions) (Concepts explained in Detailed)
MTH301 Lecture 28 (Limits of vector valued functions) (Concepts explained in Detailed)